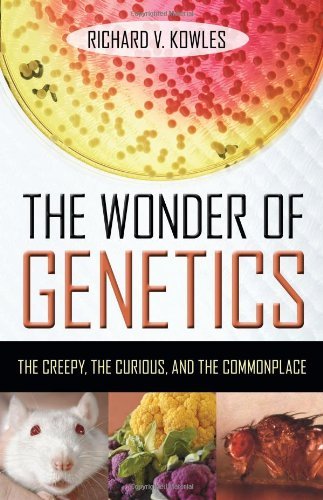

The Wonder of Genetics: The Creepy, the Curious, and the Commonplace Book PDF, ePub eBook
The Wonder of Genetics: The Creepy, the Curious, and the Commonplace.pdf
File Name: The Wonder of Genetics: The Creepy, the Curious, and the Commonplace.pdf
Size: 19.23 MB
Uploaded: 2017-04-9 02:7:32


